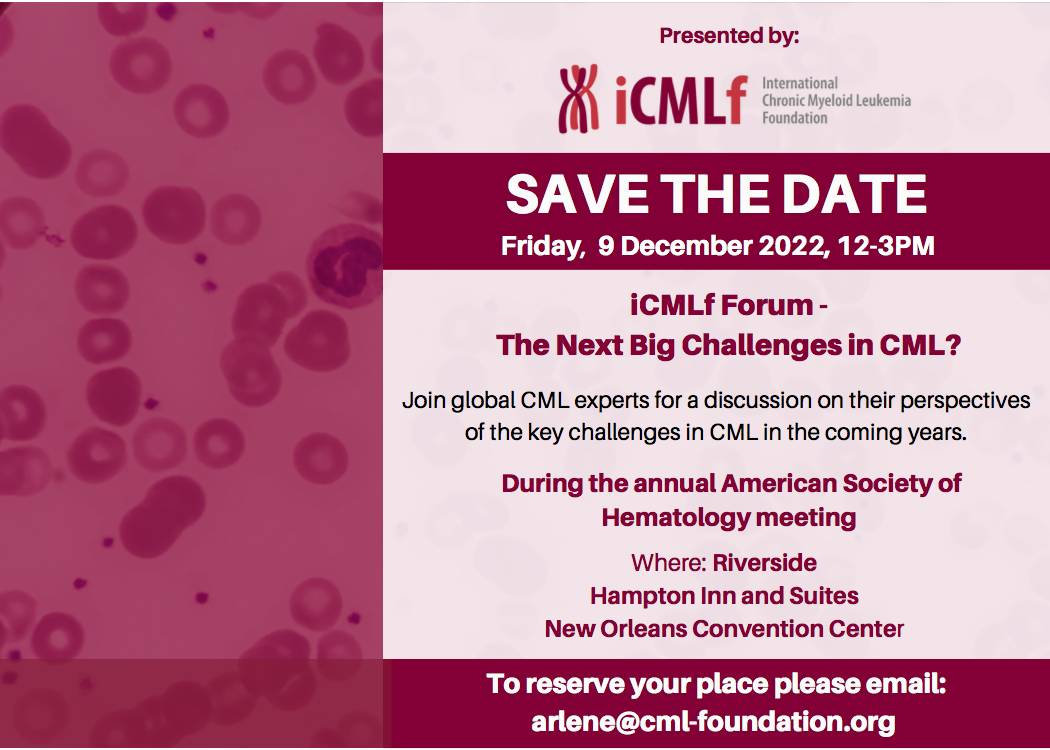
ASH Save the date Final

News
REMINDER: iCMLf Forum at ASH on Dec 9: First results of - Next big Challenges survey
 November 2022 - What are the next big challenges in CML? What are the most promising new approaches? What brings us closer to a cure for CML? These are challenging questions and finding a cure for CML is complex. However, we want to address exactly this.
November 2022 - What are the next big challenges in CML? What are the most promising new approaches? What brings us closer to a cure for CML? These are challenging questions and finding a cure for CML is complex. However, we want to address exactly this.
Do you want to help shape the discussion? Then join our speakers and panellists of renowned CML experts for the iCMLf Forum at ASH on December 9th. Details of the program can be found below. Please register ASAP by emailing arlene@cml-foundation.org as we do need to confirm numbers this week.
Even if you cannot attend the meeting in person you can still help. Participate in the survey to let us know the research questions you believe need to be answered to move us closer to a cure for CML.
Have a look at the first answers here...
Join us for CML Highlights of ASH on Dec 19th at 2 pm CET
 November 2022 - During our last iCMLf Conversation for the year, in December we will present CML highlights from this year’s American Society of Hematology (ASH) Meeting.
November 2022 - During our last iCMLf Conversation for the year, in December we will present CML highlights from this year’s American Society of Hematology (ASH) Meeting.
Professor Ravi Bhatia (Birmingham) and Professor Michael Mauro (New York) will share the significant clinical and biological updates for CML that will be presented during the meeting.
If you will not be able to attend ASH, or would just like a recap of the CML highlights, this is an opportunity to get a first-hand, expert summary fresh from the conference.
Don’t miss out, join us for the live webinar on Zoom on Monday, December 19th at 2 pm Central European Time.
YOU ARE INVITED to discuss future directions of CML at the iCMLf Forum at ASH on Dec 9
 November 2022 - We are looking forward to seeing you at the upcoming ASH Annual Meeting and welcoming you to our iCMLf Forum: ‘New next big challenges in CML?’
November 2022 - We are looking forward to seeing you at the upcoming ASH Annual Meeting and welcoming you to our iCMLf Forum: ‘New next big challenges in CML?’
At this forum, we will take a look at future directions of CML. What are the next big challenges in CML? What are the most promising new approaches? What research questions need to be answered to help us to move closer to a cure for CML?
Our speakers and panellists of renowned experts in the field will share their perspectives and discuss key challenges in CML in the coming years. You are invited to join the discussion!
Numbers are limited. Please register ASAP by emailing arlene@cml-foundation.org
Read the iCMLf’s 2021-2022 Annual Report
We’re pleased to share the 2021-2022 iCMLf Annual Report. To begin, it’s a pleasure to start with a note from the Chairman and Chief Executive.
Dear Friends and Colleagues,
This year as we slowly work our way into a new normal after the peak of the pandemic, our efforts have solidified into two key areas:
- Harnessing our power through global research
- Raising the bar for CML best practice around the world
As we began our financial year in September 2021 the Omicron variant of SARS-CoV-2 had yet to arrive and we were still collecting cases for the iCMLf COVID-19 registry. Two hundred physicians from 58 countries submitted a total of 1,050 cases giving a truly global perspective of the impact of COVID-19 on people with CML. The four publications from this registry data have all shown that people with well-controlled CML have the same risk profile as that of the general population for outcomes of COVID-19. We are incredibly proud of the work and global collaboration that resulted from this registry in spite of the devastation that made it necessary.
iCMLf Forum at ASH discusses future directions of CML - Save the date!
October 2022 - Are you coming to the ASH Annual Meeting this year? And would you like to join us for a multi-stakeholder discussion on future directions of CML?
October 2022 - Are you coming to the ASH Annual Meeting this year? And would you like to join us for a multi-stakeholder discussion on future directions of CML?
If so, please save the date for this year’s iCMLf Forum hat will take place on Friday 9th December from 12-3 pm.
Download the ‘Save-the-date’ invitation here
The 2022 John Goldman charity Fun Run raised over $1,700 so far - You can still join the run virtually!
 October 2022 - The 2022 John Goldman charity Fun Run raised over $1,700 so far. What a great achievement!
October 2022 - The 2022 John Goldman charity Fun Run raised over $1,700 so far. What a great achievement!
A special thank you to all for participating in our charity run T-shirt and to everyone for your generous contributions to support the work of the iCMLf. These funds will make a huge difference to help the iCMLf to support young scientists and physicians in low- and middle-income countries.
The good news: You can still do your own 5 km run and join the community virtually.










